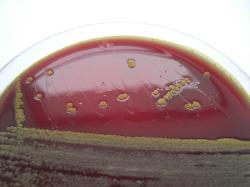

Besides the Eikenella corrodens there are other germs like some Paenibacillus (P.
agaridevorans, P. agarexedens), Campylobacter (C. gracilis), Pseudomonas (P.
stutzeri), Moraxella (M. catarrhalis), Neisseria, and Kingella. Also some streptococci
(some S. pneumoniae strains), micrococci (M. mucilaginosus), staphylococci (S.
aureus, S. epidermidis) produce slight to moderate depressions in the agar, with or
without moderate corrosion.
This test has little value for identification as there is a very variable
character, even inside the same species.
agaridevorans, P. agarexedens), Campylobacter (C. gracilis), Pseudomonas (P.
stutzeri), Moraxella (M. catarrhalis), Neisseria, and Kingella. Also some streptococci
(some S. pneumoniae strains), micrococci (M. mucilaginosus), staphylococci (S.
aureus, S. epidermidis) produce slight to moderate depressions in the agar, with or
without moderate corrosion.
This test has little value for identification as there is a very variable
character, even inside the same species.
| Pitting of sheep blood agar. Sunk colonies. |
| Agar pitting |
DESCRIPTION
Some bacteria have the metabolic ability to liquefy or degrade the agar surface, creating a corroded aspect or producing small craters
in the agar (pitting) where colonies may sunk into.
Usually the phenomena is better observed after prolonged incubation
48-72 hours.
Some bacteria have the metabolic ability to liquefy or degrade the agar surface, creating a corroded aspect or producing small craters
in the agar (pitting) where colonies may sunk into.
Usually the phenomena is better observed after prolonged incubation
48-72 hours.
REFERENCES:
1. Jane J. Alexander and Jay F. Lewis. Pitting of Agar Surface by Pseudomonas stutzeri. J Clin Microbiol. 1976 March; 3(3): 381.
2. Henriksen, S. D. (1974), “Pitting” and “Corrosion” of the Surface of Agar Cultures by Colonies of Some Bacteria from the Respiratory
Tract. Acta Pathologica Microbiologica Scandinavica Section B Microbiology and Immunology, 82B: 48–52. doi: 10.1111/j.1699-
0463.1974.
1. Jane J. Alexander and Jay F. Lewis. Pitting of Agar Surface by Pseudomonas stutzeri. J Clin Microbiol. 1976 March; 3(3): 381.
2. Henriksen, S. D. (1974), “Pitting” and “Corrosion” of the Surface of Agar Cultures by Colonies of Some Bacteria from the Respiratory
Tract. Acta Pathologica Microbiologica Scandinavica Section B Microbiology and Immunology, 82B: 48–52. doi: 10.1111/j.1699-
0463.1974.

| Antibiogram |
| Encyclopedia |
| Culture media |
| Biochemical tests |
| Stainings |
| Images |
| Movies |
| Articles |
| Identification |
| Software |
(c) Costin Stoica
| R E G N U M PROKARYOTAE |
| Back |